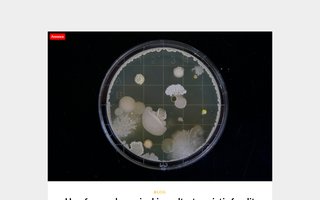

registrant: "Xcale Group ApS"
| domain | address | city | code | captured | status | |
|---|---|---|---|---|---|---|

|
bedstesundhed.dk | Hindegade 6 | København K | 1303 | 2026-03-06 | ok |

|
rsd-online.dk | Hindegade 6 | København K | 1303 | 2026-03-02 | ok |
|
empati.dk | Hindegade 6 | København K | 1303 | 2026-02-28 | ok |

|
lovemedia.dk | Hindegade 6 | København K | 1303 | 2026-02-28 | ok |

|
monitored.dk | Hindegade 6 | København K | 1303 | 2026-02-27 | ok |

|
find-den-billigste.dk | Hindegade 6 | København K | 1303 | 2026-02-25 | ok |

|
husmor.dk | Hindegade 6 | København K | 1303 | 2026-02-07 | ok |

|
kundesites.dk | Hindegade 6 | København K | 1303 | 2026-01-24 | ok |

|
elprisportalen.dk | Hindegade 6 | København K | 1303 | 2026-01-24 | ok |
|
—
|
ladeportalen.dk | Hindegade 6 | København K | 1303 | 2026-01-24 | err |

|
opstaldninger.dk | Hindegade 6 | København K | 1303 | 2026-01-23 | ok |

|
crawled.dk | Hindegade 6 | København K | 1303 | 2026-01-23 | ok |

|
sitepoint.dk | Hindegade 6 | København K | 1303 | 2026-01-23 | ok |

|
ladehotel.dk | Hindegade 6 | København K | 1303 | 2026-01-23 | ok |

|
larsbirkedal.dk | Hindegade 6 | København K | 1303 | 2026-01-23 | ok |

|
billigladeboks.dk | Hindegade 6 | København K | 1303 | 2026-01-23 | ok |

|
designtrade.dk | Hindegade 6 | København K | 1303 | 2026-01-23 | ok |

|
lennartoester.dk | Hindegade 6 | København K | 1303 | 2026-01-22 | ok |

|
stineoester.dk | Hindegade 6 | København K | 1303 | 2026-01-22 | ok |

|
ladeklar.dk | Hindegade 6 | København K | 1303 | 2026-01-22 | ok |

|
xn--personlig-trner-8lb.dk | Hindegade 6 | København K | 1303 | 2026-01-21 | ok |

|
elpristjek.dk | Hindegade 6 | København K | 1303 | 2026-01-21 | ok |

|
finddenbilligste.dk | Hindegade 6 | København K | 1303 | 2026-01-20 | ok |